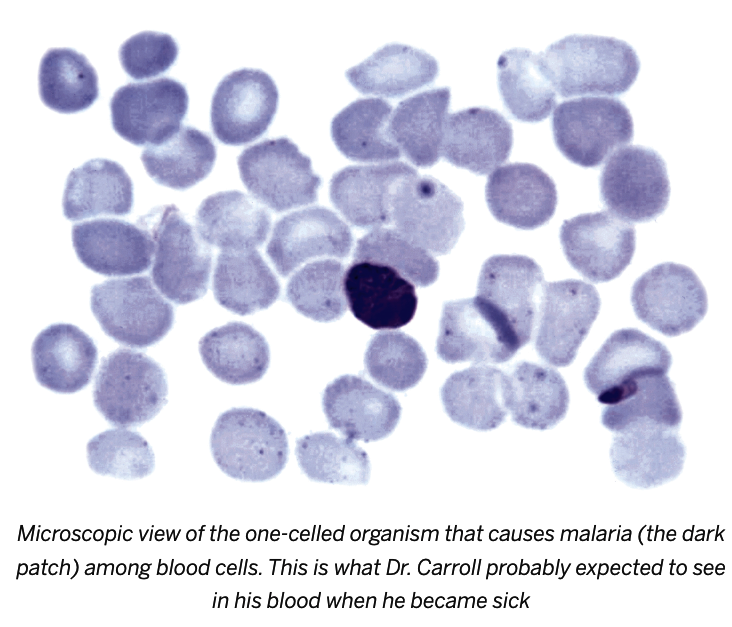

Copy of Copy of Yellow Death 7 (6/23/2025)
star
star
star
star
star
Last updated 6 months ago
17 questions
Reputation vs. Credibility
Excerpt from Chapter 2 in The Secret of the Yellow Death by Suzanne Jurmain
7 And then, finally, there was another idea. A very different one. For almost twenty years, in more than one hundred experiments, a Cuban doctor named Carlos Finlay had tried to prove that mosquito bites caused yellow fever. Time and time again, the Cuban scientist had attempted to show that bugs could carry the disease by letting mosquitoes he thought might be infected with the germ bite groups of healthy patients. But none of Finlay’s patients ever developed a truly clear-cut case of yellow fever from the bites. The experiments were unsuccessful. Many scientists laughed at the Cuban doctor’s failures. The mosquito theory didn’t seem to fit the facts, and no one understood why Finlay still continued to believe it. Maybe, some people said, the Cuban doctor was “touched.” Others came right out and called him “crazy.” Even Reed’s boss, the surgeon general of the army, George Sternberg—a leading American bacteriologist—thought that the mosquito theory was a joke. Investigating it was “useless,” he told Reed. And there was a good chance that the army surgeon general was right. Most sensible scientists did think the mosquito theory sounded pretty flaky. And Bacillus icteroides? Well, because of his own research, Reed privately thought that was probably pretty flaky, too.
1
Reread the passage from Chapter 2, where Dr. Finlay and his theory are first described.
What are two words or phrases from the passage that give you a strong sense about the credibility of Dr. Finlay and his experiments?
Reread the passage from Chapter 2, where Dr. Finlay and his theory are first described.
What are two words or phrases from the passage that give you a strong sense about the credibility of Dr. Finlay and his experiments?
1
What does the author's description suggest about Dr. Finlay's work as a scientist?
What does the author's description suggest about Dr. Finlay's work as a scientist?
Excerpt from Chapter 6 in The Secret of the Yellow Death by Suzanne Jurmain
7 At some time, possibly in late July, members of the Reed team drove up to a house on Aguacate Street in Havana. They had come to visit Dr. Carlos Finlay, the Cuban scientist who had tried for years to prove that mosquitoes carried yellow fever. For decades medical researchers around the world had laughed at “crazy” Dr. Finlay and his lunatic ideas. But the formally dressed, white-whiskered gentleman who greeted the Americans didn’t seem like a mad scientist. He was a dignified, highly educated, bespectacled sixty-seven-year-old who knew six languages—including English—and spoke all of them with a slight stutter. During the day, Dr. Finlay treated patients—whether or not they could afford to pay. At night, he devoted time to scientific research. For twenty years he’d ignored the rude remarks that others made about his work on yellow fever. For twenty years he’d continued to believe his theory. And now he was eager to share his thoughts with the others.
1
Read along with the recording from Chapter 6 of the team's first face-to-face meeting with Dr. Finlay.
What are two words or phrases from the passage that give you a strong sense about the character and credibility of Dr. Finlay?
Read along with the recording from Chapter 6 of the team's first face-to-face meeting with Dr. Finlay.
What are two words or phrases from the passage that give you a strong sense about the character and credibility of Dr. Finlay?
The Mosquito Theory
Excerpt from Chapter 6 in The Secret of the Yellow Death by Suzanne Jurmain
7 At some time, possibly in late July, members of the Reed team drove up to a house on Aguacate Street in Havana. They had come to visit Dr. Carlos Finlay, the Cuban scientist who had tried for years to prove that mosquitoes carried yellow fever. For decades medical researchers around the world had laughed at “crazy” Dr. Finlay and his lunatic ideas. But the formally dressed, white-whiskered gentleman who greeted the Americans didn’t seem like a mad scientist. He was a dignified, highly educated, bespectacled sixty-seven-year-old who knew six languages—including English—and spoke all of them with a slight stutter. During the day, Dr. Finlay treated patients—whether or not they could afford to pay. At night, he devoted time to scientific research. For twenty years he’d ignored the rude remarks that others made about his work on yellow fever. For twenty years he’d continued to believe his theory. And now he was eager to share his thoughts with the others.
8 Yellow fever, he told the team, was probably spread by the bite of one particular kind of mosquito—a striped insect that was called the Aedes aegypti (pronounced a-dees egypti) mosquito by scientists.
9 That was the first point.
10 The second point, Dr. Finlay noted, was that mosquitoes—including Aedes aegypti—spread disease by sucking blood.
11 When a mosquito bites, it is actually using its long, needlelike nose (called a proboscis) to stab through the skin and draw blood from its victim. If the mosquito bites a sick person, it sucks in germ-infected blood. Later, when that infected mosquito bites again, it uses its proboscis to inject those germs into a healthy person’s body.
12 The process is simple, but only a female mosquito can carry it out—because only a female mosquito is capable of sucking blood.
13 As a rule, both males and females eat plant juice and fruit nectar. Females, however, also need blood meals to help them manufacture the thousands of eggs that they lay in ponds, pools, puddles, and containers of still water.
14 To illustrate this point, Dr. Finlay handed the Americans a batch of tiny black “cigar-shaped” specks. They were dried Aedes aegypti eggs that he had recently scooped out of a bowl of water in his own library. If those eggs were placed in water and kept relatively warm, Finlay told the team, they would grow into adult mosquitoes in about two weeks.
1
Reread the explanation of Dr. Finlay’s mosquito theory.
What is Dr. Finlay’s theory? Order the steps of the doctor's theory about how a mosquito spreads yellow fever.
Reread the explanation of Dr. Finlay’s mosquito theory.
What is Dr. Finlay’s theory? Order the steps of the doctor's theory about how a mosquito spreads yellow fever.
- When that mosquito later bites a person, it injects yellow fever germs into that person.
- The healthy person becomes infected with yellow fever.
- A female mosquito bites a person with yellow fever.
- That mosquito becomes infected with yellow fever.
Work Visually
Excerpt from Chapter 6 in The Secret of the Yellow Death by Suzanne Jurmain
16 First, he would hatch the eggs that Dr. Finlay had provided and raise a crop of Aedes aegypti mosquitoes that had never been exposed to any illness. Then he would have the females bite a group of yellow fever patients so that the disease-free bugs could pick up the infection. Finally, to prove that the insects could actually carry the disease germ, Dr. Lazear would have to allow female Aedes aegypti mosquitoes that had bitten yellow fever patients to bite healthy animals or humans. Then he would have to see if the healthy creatures developed the disease.
1
Dr. Lazear designs the experiment that he will use to test Dr. Finlay’s theory about the role mosquitoes play in the transmission of yellow fever.
What was one hypothesis that the team could investigate with this experiment? Complete the if/then statement to identify a hypothesis.If infected mosquitoes spread yellow fever, then
Dr. Lazear designs the experiment that he will use to test Dr. Finlay’s theory about the role mosquitoes play in the transmission of yellow fever.
What was one hypothesis that the team could investigate with this experiment? Complete the if/then statement to identify a hypothesis.
If infected mosquitoes spread yellow fever, then
1
Create a comic strip showing the steps of Dr. Lazear’s mosquito experiment to test Dr. Finlay’s mosquito theory. Match the captions with the appropriate images.

Other Answer Choices:
The infected mosquito is allowed to bite a healthy test subject.
The test subject is observed for signs of the disease.
Healthy mosquitoes hatch from tiny, cigar-shaped eggs kept in water.
A female mosquito uses her proboscis to draw blood from a person who is infected with yellow fever.
That mosquito becomes infected with yellow fever.
1
Use your comic strip and the text to complete the following sentences.
Dr. Lazear will hatch mosquitoes because _______
Dr. Lazear will let female mosquitoes bite people who are infected with yellow fever because _______
Dr. Lazear needs to have the infected mosquitoes bite healthy people because _______
1
Compare the written presentation of Lazear's experiment with the comic version. What are the advantages and disadvantages of each?
Compare the written presentation of Lazear's experiment with the comic version. What are the advantages and disadvantages of each?
Homework
Excerpt from Chapter 6 in The Secret of the Yellow Death by Suzanne Jurmain
7 At some time, possibly in late July, members of the Reed team drove up to a house on Aguacate Street in Havana. They had come to visit Dr. Carlos Finlay, the Cuban scientist who had tried for years to prove that mosquitoes carried yellow fever. For decades medical researchers around the world had laughed at “crazy” Dr. Finlay and his lunatic ideas. But the formally dressed, white-whiskered gentleman who greeted the Americans didn’t seem like a mad scientist. He was a dignified, highly educated, bespectacled sixty-seven-year-old who knew six languages—including English—and spoke all of them with a slight stutter. During the day, Dr. Finlay treated patients—whether or not they could afford to pay. At night, he devoted time to scientific research. For twenty years he’d ignored the rude remarks that others made about his work on yellow fever. For twenty years he’d continued to believe his theory. And now he was eager to share his thoughts with the others.
8 Yellow fever, he told the team, was probably spread by the bite of one particular kind of mosquito—a striped insect that was called the Aedes aegypti (pronounced a-dees egypti) mosquito by scientists.
9 That was the first point.
10 The second point, Dr. Finlay noted, was that mosquitoes—including Aedes aegypti—spread disease by sucking blood.
11 When a mosquito bites, it is actually using its long, needlelike nose (called a proboscis) to stab through the skin and draw blood from its victim. If the mosquito bites a sick person, it sucks in germ-infected blood. Later, when that infected mosquito bites again, it uses its proboscis to inject those germs into a healthy person’s body.
12 The process is simple, but only a female mosquito can carry it out—because only a female mosquito is capable of sucking blood.
13 As a rule, both males and females eat plant juice and fruit nectar. Females, however, also need blood meals to help them manufacture the thousands of eggs that they lay in ponds, pools, puddles, and containers of still water.
14 To illustrate this point, Dr. Finlay handed the Americans a batch of tiny black “cigar-shaped” specks. They were dried Aedes aegypti eggs that he had recently scooped out of a bowl of water in his own library. If those eggs were placed in water and kept relatively warm, Finlay told the team, they would grow into adult mosquitoes in about two weeks.
Required
1
Based on your understanding of Dr. Finlay’s theory, which caption best describes this image?
Based on your understanding of Dr. Finlay’s theory, which caption best describes this image?
Required
1
“For twenty years he’d ignored the rude remarks that others made about his work on yellow fever. For twenty years he’d continued to believe his theory. And now he was eager to share his thoughts with others.” (Chapter 6, 7)
Why does the author write "For twenty years he’d continued to believe his theory" instead of "For twenty years he knew he was right"? Select the two best answers.
“For twenty years he’d ignored the rude remarks that others made about his work on yellow fever. For twenty years he’d continued to believe his theory. And now he was eager to share his thoughts with others.” (Chapter 6, 7)
Why does the author write "For twenty years he’d continued to believe his theory" instead of "For twenty years he knew he was right"? Select the two best answers.
Excerpt from Chapter 7 in The Secret of the Yellow Death by Suzanne Jurmain
1 August 1–30, 1900
2 It sounded so simple. All Lazear had to do was put the mosquito eggs in water, keep the water in a warm place, and wait a couple of weeks until the eggs hatched and grew into mature insects.
3 But it wasn’t that easy. Some eggs just floated on the water and didn’t hatch. Some insects died before they were completely grown up. Others dropped dead almost as soon as they became adults. Still, Lazear didn’t give up. He tended his mosquitoes as if they were babies. Each day, he checked the progress of his little group. He made sure the adult insects were fed sweetened water and bits of banana. Sometimes he even let the females bite him and his lab attendants to make sure that they had nourishing drinks of blood. At last, when the insects were fully grown, Dr. Lazear put each mature female in a test tube. He plugged the opening with a fluffy cotton stopper and carried his tubes of mosquitoes to the yellow fever wards at Las Animas Hospital in Havana.
4 On the hot August days, Lazear walked through the wards, stopping occasionally at a yellow fever patient’s bedside to let one of his female mosquitoes bite.
5 It was a delicate process. First he turned the tube upside down so that the mosquito would fly upward into the glass end of the tube. Then Lazear swiftly removed the cotton plug and placed the open end of the tube flat on the patient’s arm or belly. Patiently, he watched as the mosquito settled, inserted its proboscis through the skin, and sucked. After that, Lazear waited until the insect flew toward the top of the container. Then he picked up the tube, replaced the stopper, and noted down the date, the name of the patient who had been bitten, the number of days the patient had been ill, and the severity of the case. After several days passed, he let each one of these “infected” mosquitoes bite himself or another healthy volunteer.
6 But nothing happened. No one got sick.
7 Was the mosquito theory wrong? Was it another dead end?
8 The results were discouraging. Scientific progress, however, doesn’t usually happen overnight, and Jesse Lazear was trying to be patient. Day after day, he tended his bugs. He wrote up his notes, and—even when he wasn’t thinking about bugs—he must have worried. Far away, back in the States, his wife was lying in a hospital, suffering through complications of her second pregnancy. The baby was due any day, and Jesse Lazear was waiting for news.
9 August 15 passed. Then August 20. Finally, on August 25 a telegram arrived. Dr. Lazear’s wife had successfully given birth to their second child, a baby girl. Of course, Lazear wouldn’t actually get to meet his new daughter until he went home for a few weeks of leave in October. But it was a wonderful thing to think about. And by the end of August, Jesse Lazear probably needed all the wonderful thoughts that he could get, because his insect experiments were going very badly.
10 For weeks Lazear had pinned his hopes on the mosquito theory. For weeks he’d waited for a breakthrough. But by August 25 Jesse Lazear had tried to use mosquitoes to produce yellow fever in healthy people on nine distinct occasions. All his experiments had failed. Many of his bugs had died. Almost every day there were new frustrations, and the events on August 27 were all too typical. On that day an insect, one that had bitten a yellow fever patient on the second day of his sickness twelve days earlier, refused to bite another volunteer at Las Animas Hospital. Worse still, the bug looked weak. Lazear figured it would probably spoil his experiment by dying before morning, but he brought it back to the laboratory at Camp Columbia anyway.
11 Carroll was in the lab when Lazear came in, and the two men began to chat about the insect work. The truth was the mosquitoes seemed absolutely “harmless.” Keeping them alive had become a major nuisance—and, in passing, Lazear told Carroll how his sickly bug had behaved that very morning.
12 Carroll had never believed in the mosquito theory, but he could easily see his colleague needed help. Since there was a chance that blood would help perk up the little insect, Carroll offered to let the feeble bug bite him.
13 At two p.m. Lazear turned the test tube upside down on Carroll’s arm. He held it in place, and waited for the feeble mosquito to fly down and suck.
14 But the bug refused to settle. It fluttered here and there, landing again and again on the smooth sides of the tube. Minutes passed. The two men waited. Then, finally, Carroll took the tube out of Lazear’s hand. He held it against his own arm and sat there patiently until, at last, the insect landed, bit, and drank its fill.
15 That took care of that.
16 Lazear put his test tubes full of bugs away, and Carroll went on with his lab work.
17 Later that week, on August 30, James Carroll and Alva Pinto, another army doctor, went down to a nearby beach to take a swim. The water was warm, but suddenly Carroll felt a chill. Moments later he had a headache—a fierce headache that seemed to be burning a hole straight through his brain. The pain was terrible, and by the time Carroll pulled himself out of the ocean, he didn’t look well. Dr. Pinto glanced in his direction, saw the bacteriologist, and made an instant diagnosis. “Yellow fever,” he said succinctly.
18 “Don’t be a . . . fool,” Carroll responded. “I have no such thing.”
Required
1
What is the author’s main purpose for writing paragraph 5?
What is the author’s main purpose for writing paragraph 5?
Excerpt from Chapter 8 in The Secret of the Yellow Death by Suzanne Jurmain
1 August 31–September 4, 1900
2 Of course, James Carroll had always known that Cuba was full of dangerous diseases. He’d known that coming to the island was a risk. And, yes, the bite from Lazear’s sickly little bug could possibly have given him the fever. But James Carroll had never believed in the mosquito theory. He’d never thought that insects carried the disease. Besides, he couldn’t afford to get the illness. He was a forty-six-year-old married man with five small children to support—and yellow fever often killed people over forty.
3 Still, there was no getting around the fact that his temperature was rising. Something was making him sick. And he needed to know exactly what the illness was.
4 It might be malaria. That could cause high fevers. It was a bad disease; but, still, it could be treated. It wasn’t usually as deadly as yellow fever. Besides, malaria was often found in Cuba. Carroll could have picked up the infection. And the scientist knew there was an easy way of finding out.
5 Early in the morning on August 31, James Carroll dragged himself over to the lab. He jabbed himself with a needle and drew some blood. Then he smeared it on a glass slide and put the slide under the microscope. Carefully, he peered through the eyepiece, focused the lenses, and began to look.
6 For several minutes he scanned the slide. There were plenty of roundish red cells. There were a few irregularly shaped white cells. But no definite sign of malaria—or of yellow fever. The trouble was, that didn’t prove a thing. Diagnosing illness with a microscope was often difficult. Sometimes yellow fever patients had fewer white cells in their blood. But often yellow fever blood looked pretty normal. And malaria? That was tricky, too. Sometimes it was hard to see the tiny organisms that caused the illness in a single drop of blood.
7 Clearly, the microscope wasn’t going to provide a simple answer. And as James Carroll looked up from the eyepiece, he must have known that there was nothing else to do but wait.
8 If it was malaria, he’d know it soon. There would be violent, periodic fevers, vomiting, sores around his lips, and soaking sweats. And if it was yellow fever, well, he’d recognize the bloodshot eyes, the bleeding nose and gums, and the awful yellow skin. One way or another, he’d find out about his illness soon enough.
9 Nobody knows how long Carroll sat in front of his microscope that morning. But he was still there when Lazear and Agramonte walked through the laboratory door—and stared. Carroll looked awful. His face was flushed; his eyes were red. But he tried to joke. The illness was nothing, he said. He’d just somehow “caught cold.”
10 Both doctors begged him to go to bed. Carroll, however, was a stubborn man. As a youngster he’d struggled against poverty. He’d fought to go to medical school. He was used to hardships, and he wasn’t the sort who’d let a little bout of sickness beat him down. Still, finally, he agreed to stretch out on a sofa.
11 It didn’t help. By afternoon, James Carroll was lying in the hospital. At seven p.m. his temperature had reached 102. Soon there was no question about the diagnosis: the scientist had come down with yellow fever.
12 But how could he have gotten the disease? In a state bordering on panic, Lazear and Agramonte reviewed the possibilities.
13 Could it have happened when Carroll visited the autopsy room at Las Animas Hospital in Havana a few days earlier? Could that be where he’d picked up the infection?
14 Or had it happened in the Camp Columbia lab when Carroll let Lazear’s enfeebled little insect bite his arm?
15 Both doctors knew that there was only one good way to find an answer. They would have to let the mosquito that bit Carroll bite another person. Then they would have to see if that victim developed a clear-cut case of the disease.
16 The experiment was basically simple. But to do it, they had to have a healthy volunteer.
17 Agramonte wasn’t a good candidate. There was a chance he’d had a very mild case of yellow fever while growing up in Cuba and now might be completely immune to the disease.
18 Lazear wasn’t a great choice either. He’d already been bitten several times by mosquitoes that had previously bitten yellow fever patients. Since those bites hadn’t made him sick, there was a chance he, too, might actually be immune to the disease.
19 A fresh volunteer would be best.
20 The scientists had barely come to that conclusion when Private William Dean walked by the lab and happened to look in.
21 Dean, a young unmarried man, had just arrived in Cuba. He’d never been near Carroll or any other yellow fever victims, but he had certainly heard a lot about the team’s experiments.
22 “You still fooling with mosquitoes, Doctor?” Dean asked, as he stood in the doorway.
23 “Yes,” said Lazear. ‘Will you take a bite?”
24 “Sure. I ain’t scared of ’em,” Dean replied.
25 Lazear looked at Agramonte. Agramonte nodded. The young private seemed to be the perfect volunteer.
26 Dr. Lazear picked up the tube containing the mosquito that had bitten Carroll. He inverted the tube, pulled out the cotton plug, and placed the opening flat against Dean’s bare arm. The bug flew down, and all three men waited while it settled on the soldier’s skin, inserted its proboscis, and sucked blood.
27 For the next few days, Lazear and Agramonte didn’t tell anyone at Camp Columbia about Carroll’s mosquito bite or Dean’s. Instead, they tried to work. They worried about Carroll, and they wondered privately if young Dean was going to get sick.
28 Carroll himself lay in the hospital, fighting the disease. Roger Ames, the army doctor with the most experience in treating yellow fever, monitored the patient and saw the scientist’s temperature rise to 104. He watched as Dr. Carroll’s skin and bloodshot eyes turned lemon yellow. The sick man’s pulse was slow. His condition was definitely critical, but there was very little Dr. Ames could do. Available drugs like quinine, castor oil, mercury compounds, and opium had no effect on yellow fever. To combat the disease, Ames ordered nurses to keep the patient quiet. He made sure that Dr. Carroll ate nothing while the fever soared but insisted that the scientist sip lemonade or water every hour.
29 At one point Carroll felt a sharp pain in his chest that seemed to stop his heart. Sometimes he babbled feverishly. But experiments were often on his mind. Once, when he ordered his nurse, Ms. Warner, to give the lab mosquitoes a meal of ripe banana, she obligingly obeyed. But when Dr. Carroll said that a mosquito bite had caused his illness, Nurse Warner was seriously shocked. A mosquito causing yellow fever? Why, everybody knew that Finlay’s theory was a joke. The whole idea was crazy, and, before she went off duty, Ms. Warner had formed her own opinion of the sick man’s silly statement. “Patient delirious,” she note briefly on the chart.
Required
1
What do the bolded sentences reveal about Dr. Carroll?
“Besides, he couldn’t afford to get the illness. He was a forty-six-year-old man with five small children to support— and yellow fever often killed people over forty.” (2)
What do the bolded sentences reveal about Dr. Carroll?
“Besides, he couldn’t afford to get the illness. He was a forty-six-year-old man with five small children to support— and yellow fever often killed people over forty.” (2)
Required
1
Based on the information in this passage, which of the following sentences best represents the author’s point of view about Dr. Carroll's character?
Based on the information in this passage, which of the following sentences best represents the author’s point of view about Dr. Carroll's character?
Required
1
Why do Dr. Agramonte and Dr. Lazear decide that they need to let the same mosquito that bit Dr. Carroll bite another healthy person?
Why do Dr. Agramonte and Dr. Lazear decide that they need to let the same mosquito that bit Dr. Carroll bite another healthy person?
Required
1
Why is Private Dean the “perfect volunteer”?
Why is Private Dean the “perfect volunteer”?
Required
1
Read the passage and copy and paste one powerful detail that the author uses to illustrate Dr. Carroll’s condition.
Read the passage and copy and paste one powerful detail that the author uses to illustrate Dr. Carroll’s condition.
Required
1
What does this detail reveal about Dr. Carroll’s condition?
What does this detail reveal about Dr. Carroll’s condition?